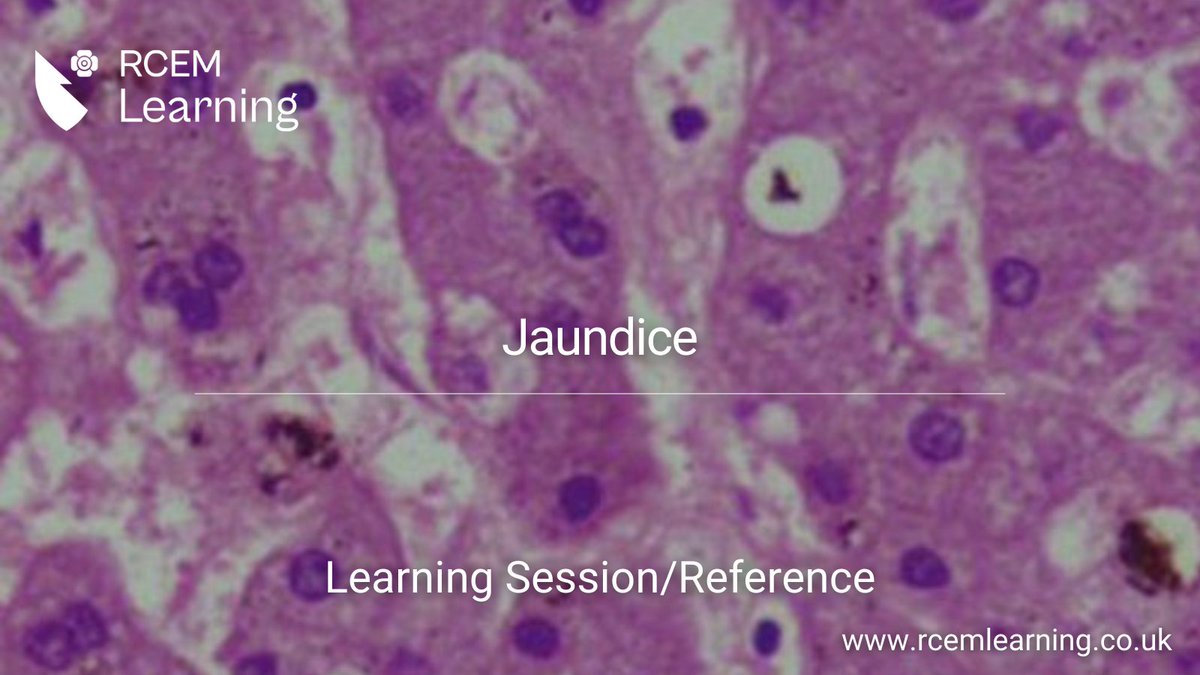
RCEMLearning's tweet image. UPDATED: This session deals with the assessment and management of jaundice. 

Learning Session🔒: rcemlearning.co.uk/modules/jaundi…
Reference🆓: rcemlearning.co.uk/reference/jaun…

Deepankar Datta
@deepankardatta
Emergency Medicine Consultant, Glaswegian-exile in Edinburgh, #FOAMed, views are my own. @[email protected]
You might like
With credit to u/quertyquerty321123 I’d like to show you all a table illustrating where doctors fall across the NHS pay scales. An FY1 is paid less than a band 5. An FY2 is paid less than a band 6. An ST2 is paid less than a band 7. Thanks to r/jduk for this table.

Remember doing a story back in 2018 saying that roaming charges were going to return for British travellers after Brexit. Govt at the time said it was v unlikely because companies wouldn’t do it. Others dismissed as more scaremongering etc. A few years later 👇

V short 🧵asking why 🏴offered 17.9% to jnrs over 3 yr(21-24) vs shambolic offer in England🏴9.2% over 2 yr (2%/2%/5%). BOTH offer massive pay cuts vs inflation But why are ScotGov getting round the table v SoS refusing? Even @ScotTories saying "get back round the table" Pls RT
1/ 🧵Hi Dr @Sandeshgulhane MP (@ScotTories) Can I ask a favour please? Its really pleasing to see a @Conservatives MP (& also GP) asking government to "get back round the table" to find a solution to the dispute, after Scottish junior docs rejected their pay offer and announced

Updated 4 nation #pensionogram v1.4 👇 Some minor changes in bold. My current understanding of NHS pensions / pension taxation / peri-retirement for the 23/24 tax year bit.ly/pensionometer

Compare the average *BASE* salary of a neurosurgeon in the USA, versus the attractive offer the UK is offering The UK applicant may well have 5+ training years on the US equivalent, due to training length This post offers 9.5% of the US average base salary Pathetic 😳

The UK needs a hard reset


My first ever poster in an International Conference. Happy to get a spotlight in the largest Emergency Conference of the world ICEM 2023, Amsterdam, the Netherlands.
Poster at #ICEM2023 new for me - Salbutamol associated lactic acidosis. Asthmatic patient increasingly breathless, lots salbutamol given. High lactate , no wheeze, normal/high pH. Easy mistake clinically = worse asthma leading to more salbutamol. Treat = stop salbutamol. @ ICEM23

Few people outside EM understand what actually happens. Poor understanding leads to poor decisions. A Sankey chart is an excellent way of quickly communicating the complexity and effectiveness of an ED. This is my ED in 2021.. #resusciateemergencycare #ICEM2023

FYI #ICEM2023….final text of the new World Health Assembly resolution on Emergency, Critical and Operative Care and Health Security (76.2) now available online: apps.who.int/gb/ebwha/pdf_f…
Thanks to the organising committee of @ICEM23 and @IFEM2 for an excellent and inspiring few days with #emergencymedicine colleagues from around the world. I enjoyed all of it, making new friends, and especially getting involved with the teaching at the marketplace stall.

Would support this view of using this kind of device that can insert under direct vision but with backup. Keeps skills for equipment failure / no VL device (not everyone can afford VL), esp. maintaining DL skills for major incidents or disaster medicine
videolaryngoscopy using a standard-geometry MAC blade adds goodness without losing anything nice view & you want to intubate under direct vision? super - go for it! difficulty & you want video help? sure, look at the screen everyone sees your progress & seamlessly assists
The amazing local Organising Committee for #ICEM2023 You did a brilliant job @IFEM2 @IFEMPresident

“Doctors are increasingly the scapegoats of systemic problems within the health care system,” Masood says, “because the patient is not seeing the insurance company that denied them the procedure, they’re not seeing the EMR that are taking all of our time.” nytimes.com/2023/06/15/mag…
nytimes.com
The Moral Crisis of America’s Doctors (Published 2023)
The corporatization of health care has changed the practice of medicine, causing many physicians to feel alienated from their work.
Last day of @ICEM23, my slide photography skills are getting worse, but enjoying switching between the environmental and disaster medicine streams (they might be related). Enjoying listening to my colleague @BaliGoma speaking about natural disasters in India. #ICEM2023

UPDATED: This session deals with the assessment and management of jaundice. Learning Session🔒: rcemlearning.co.uk/modules/jaundi… Reference🆓: rcemlearning.co.uk/reference/jaun…
Poster at #ICEM2023 new for me - Salbutamol associated lactic acidosis. Asthmatic patient increasingly breathless, lots salbutamol given. High lactate , no wheeze, normal/high pH. Easy mistake clinically = worse asthma leading to more salbutamol. Treat = stop salbutamol. @ ICEM23

Language changing. It used to be “both sides” need to come together Now it is “government must…” Realisation of where the roadblocks to this dispute lie are now being shared by senior NHS officials
videolaryngoscopy using a standard-geometry MAC blade adds goodness without losing anything nice view & you want to intubate under direct vision? super - go for it! difficulty & you want video help? sure, look at the screen everyone sees your progress & seamlessly assists
We have a new report out today by @Samfr & @racheljanetwolf on the hospital productivity puzzle. We identify 3 key reasons: 1) longstanding underinvestment in capital (beds, scanners, buildings) 2) the loss of senior staff 3) chronic undermanagement instituteforgovernment.org.uk/publication/nh…

📌 Have you visited the ICEM 2023 Poster Presentations yet? Navigate through the aisles, check the visuals and the thoughtfully crafted content. Engage in meaningful conversations and exchange ideas. Explore them all next to the Auditorium. #icem2023 #amsterdam #emergencymedicine




This gal absolutely bossed it!!!! @bec_caulfield presenting on factors preceding occupational distress in ED nurses! Clearly passionate about this topic and confident with the content. Fantastic representation for the ED nursing workforce presenting at this level. 👏👏👏

Ian Roberts #ICEM2023 “Large clinical trials are designed using logic, but delivered using human relationships.” @CTU_LSHTM
United States Trends
- 1. Dodgers N/A
- 2. #TheTraitorsUS N/A
- 3. Mets N/A
- 4. #TNAiMPACT N/A
- 5. Colton N/A
- 6. World Series N/A
- 7. Baseball N/A
- 8. Yankees N/A
- 9. Bellinger N/A
- 10. #TNAonAMC N/A
- 11. Skubal N/A
- 12. Nobel Peace Prize N/A
- 13. Cohen N/A
- 14. Lockout N/A
- 15. Ohtani N/A
- 16. Draymond N/A
- 17. #thepitt N/A
- 18. Tiffany N/A
- 19. Soto N/A
- 20. The MLB N/A
Something went wrong.
Something went wrong.































































































































